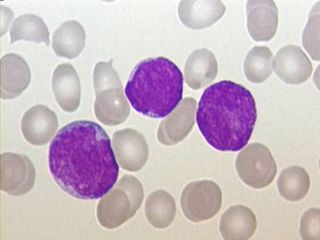
białaczka

Baza imion
Obliczanie terminu porodu
Kalkulatory
Kalendarz ciąży
Rozwój dziecka
Siatki centylowe
Grupa Facebook
Serwis Dzidziusiowo

Kariera zawodowa bitych kobiet
2011-10-27
Bycie finansowo zależną od swojego partnera jest jedną z najczęściej podawanych przyczyn trwania w patologicznym związku. Kobiety, z obawy przed utratą dachu na...

Prolaktyna. Hormon macierzyństwa i ojcostwa - Dzidziusiowo.pl
2011-10-27
Prolaktyna, zwana również "mlecznym hormonem", wytwarzana jest w przysadce mózgowej i odpowiada m.in. za prawidłowy przebieg menstruacji, pobudzanie gruczołów m...

ZZO a przebieg porodu
2011-10-27
Znieczulenie zewnątrzoponowe to obecnie najpopularniejszy sposób na uniknięcie bólu porodowego. Jest tak skuteczne, że w niektórych przypadkach może go wyelimin...

Zależne od partnera - kata
2011-10-27
Wiele badań pokazuje, że osoby doznające przemocy ze strony swych partnerów napotykają na poważne trudności w wykonywaniu pracy zawodowej. Wiele z nich ma obniż...

Beta-endorfiny zamiast bólu
2011-10-27
Endorfiny mają działanie przeciwbólowe i poprawiające nastrój. Wydzielane są pod wpływem stresu, akupunktury czy wysiłku fizycznego, ale także na myśl o ulubion...

Pępowina - kiedy należy ją odciąć? - Dzidziusiowo.pl
2011-10-26
Pępowina nie powinna zostać odcięta od razu po porodzie, ale dopiero, gdy przestanie tętnić. Dopiero wtedy cała krew z łożyska spłynie do dziecka. Późne odcięci...

Tokofobia - lęk przed ciążą
2011-10-26
Tokofobia, inaczej zwana parturifobią, to patologiczny strach przed ciążą i porodem. Tokofobia zaliczana jest do zaburzeń lękowych. Kobiety z powodu patologiczn...
Białaczka
2011-10-26
Białaczka to choroba nowotworowa dotykająca ludzi w każdym wieku. Jej nazwa wiąże się z często występującym objawem zaawansowanego stadium choroby - zwiększoną ...

Oksytocyna na szczęście
2011-10-26
Prawdopodobnie najlepiej poznanym hormonem obecnym podczas porodu jest oksytocyna. Zwana jest "hormonem miłości", ponieważ wydziela się w trakcie aktywności sek...

Korzyści i niebezpieczeństwa późnego odcięcia pępowiny
2011-10-24
Odcięcie pępowiny zaraz po porodzie wydaje się być czymś oczywistym. Jednakże badania wykazują wiele korzyści związanych z tzw. późnym odpępnieniem. Warto rozwa...

Poród - jak rozpoznać, czy to już, czy kolejny fałszywy alarm
2011-10-20
Co do prawdopodobnego rozpoczęcia porodu wczesnych, sugerujących start akcji porodowej objawów jest sporo. Jednak są także takie, które wyraźnie mówią: „Tak to ...

Pępkowe – czyli żona cierpi, a ja piję
2011-10-20
Mówi się często, że „okazja do wypicia zawsze się znajdzie”. Jednak tylko dwie okazje doczekały się nazwy własnej: parapetówka i pępkowe. Są to niewątpliwie wyd...

Kiedy rozpoczyna się ojcostwo?
2011-10-20
O instynkcie macierzyńskim pisze i mówi się wiele. Nikt nie zaprzecza jego istnieniu, choć tak naprawdę tylko matki wiedzą, co on w rzeczywistości oznacza. Za s...

Masturbacja u dzieci
2011-10-10
Masturbacja czyli samogwałt lub też onanizm, to autoerotyczna forma zaspakajania popędu płciowego poprzez drażnienie narządów płciowych. Obecność tego typu zach...

Poród rodzinny – za i przeciw
2011-10-10
Dla wielu kobiet poród to bardzo trudne doświadczenie. Zwłaszcza, że wcześniej miały one okazję nasłuchać się od swoich koleżanek o tym, jak bardzo niemiłe i bo...

Wybór żłobka - czym się kierować? Jak wybrać najlepszy? | Dzidziusiowo.pl
2011-10-10
Żłobek to instytucja opiekuńczo – wychowawcza dla dzieci do lat trzech. Maluchy mają tam zapewnioną odpowiednią opiekę oraz warunki do rozwoju psychicznego i fi...

Damski bokser – bije ale kocha
2011-10-05
Był najcudowniejszym człowiekiem, którego w życiu spotkałaś. Teraz zastanawiasz się, czy to wciąż ten sam mężczyzna. Znęca się nad Tobą, bije i upokarza, po czy...

Dlaczego szukamy księcia z bajki?
2011-10-05
Jak powinien wyglądać i jaki powinien być ten jeden, jedyny? Niemal każda kobieta na to pytanie posiada już swoją odpowiedź. Dobrze, gdyby był wysoki, a może ni...
